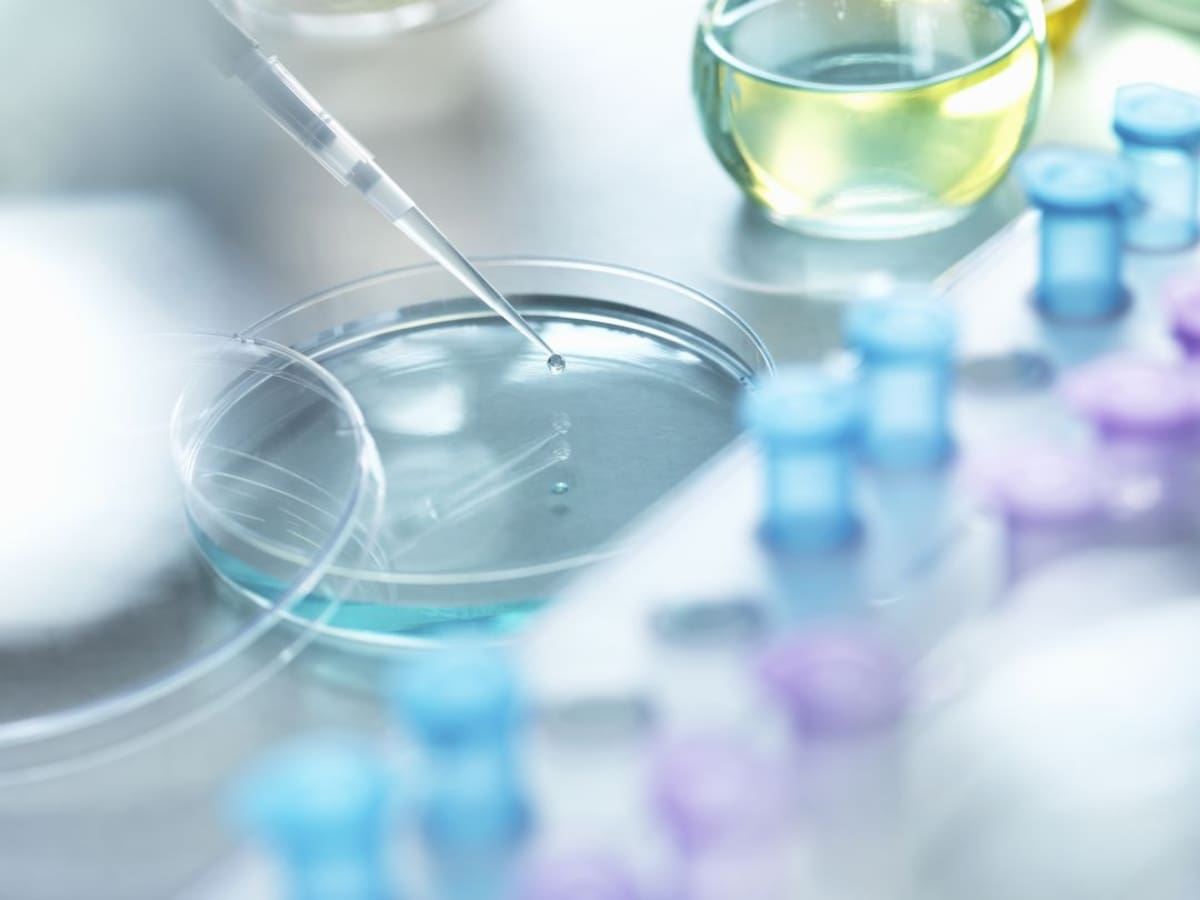

La montaña no es un parque de atracciones
Analizamos las imprudencias más habituales al salir a la montaña y el coste que podría acarrear un rescate
10/11/2018 - 12:17
Diego Merayo
Valladolid
Selecciona tu emisora
Es locutor, redactor y productor en Radio Valladolid, emisora en la que desarrolla su carrera profesional desde 2003. Presenta 'A vivir que son dos días Castilla y León'. Interesado en la actualidad y las nuevas tecnologías. Lleva el Bierzo, su tierra, siempre en el corazón.

Analizamos las imprudencias más habituales al salir a la montaña y el coste que podría acarrear un rescate
10/11/2018 - 12:17
Diego Merayo
Valladolid

Con la sexóloga Rosa Montaña hablamos del respeto en cualquier relación personal
06/11/2018 - 18:46
Diego Merayo
Valladolid

La sexóloga Rosa Montaña nos enumera alguna de las razones más frecuentes por las que rompemos una relación
30/10/2018 - 18:46
Diego Merayo
Desde la asociación de Investigadores de Castilla y León advierten del peligro que corremos al producir unos empleos tan inestables en investigación
27/10/2018 - 13:39
Diego Merayo
Valladolid

Con el comienzo de la campaña de vacunación llega la polémica: ¿debe vacunarse el personal sanitario?
20/10/2018 - 19:01
Diego Merayo
Valladolid

Asociaciones y profesionales demandan más recursos en cuidados paliativos en Castilla y León
13/10/2018 - 13:41
Diego Merayo
Valladolid

El 12 de octubre cambia el etiquetado de los combustibles en toda la Unión Europea
09/10/2018 - 19:11
Diego Merayo
Valladolid

CCOO pone en marcha en Valladolid una campaña para visitar oficinas y despachos con el fin de erradicar el acoso en el entorno laboral
03/10/2018 - 12:51
Diego Merayo
Valladolid

La D.O. Rueda lleva más de una década vendimiando sus verdejos por la noche para evitar la oxidación de la uva y ahorrar en energía
02/10/2018 - 13:21
Diego Merayo
Valladolid

El Banco de Tejidos Neuronales de Castilla y León cuenta con 48 cerebros para que grupos científicos de todo el mundo investiguen las enfermedades que afectan a este órgano
29/09/2018 - 13:13
Diego Merayo
Valladolid

El Colegio Profesional advierte que los peligros para la salud son grandes si nos ponemos en manos de profesionales sin titulación
15/09/2018 - 13:39
Diego Merayo
Valladolid

Después de que el TSJCyL haya anulado dos ordenes de la convocatoria actual, la asociación de profesores de Enseñanza Secundaria aseguran que "la pelota está en el tejado de la Junta"
25/07/2018 - 19:01
Diego Merayo
Valladolid

Alberto Arzua, vicepresidente de la Unión de consumidores de Castilla y León, nos da los consejos necesarios para reclamar en caso de que nos afecte la huelga de la compañía irlandesa
20/07/2018 - 19:42
Diego Merayo
Valladolid

El vicepresidente de la sociedad castellana y leonesa de medicina de familia y comunitaria, Eduardo Lamarca, nos cuenta cómo es el trabajo en el mundo rural
17/07/2018 - 19:28
Diego Merayo
Valladolid
Ahora en directo
Cadena SER
00:00 - 23:59
00:00 - 23:59
Otros directosCadena SER
00:00 - 23:59
Podcast
Síguenos en
Otros episodios
Cualquier tiempo pasado fue anterior
Tu audio se ha acabado.
Te redirigiremos al directo.
5 "